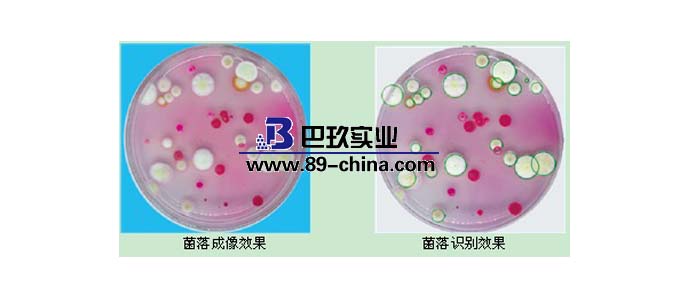
菌落計數(shù)器

菌落計數(shù)器各類問題匯總
目錄:
菌落計數(shù)器是指用于統(tǒng)計物品中含菌落進行計數(shù)的儀器。目前菌落計數(shù)器一般具有能夠分析菌落大小、顏色、隆起狀況、密集性和蔓延性等特點,能夠有效減輕實驗檢測人員的工作效率,提高工作質(zhì)量。
菌落計數(shù)器是一種數(shù)字顯示式自動細菌檢驗儀器。由計數(shù)器、探筆、計數(shù)池等部分組成,計數(shù)器采用CMOS集成電路精心設計,LED數(shù)碼管顯示,字高13mm,清晰明亮,配合專用探筆,計數(shù)靈敏[accuracy],菌落對比清楚。便于觀察。可廣泛用于食品、飲料、藥品、生物制品、化妝品、衛(wèi)生用品、飲用水、生活污水、工業(yè)廢水、臨床標本中細菌數(shù)的檢驗。是各級防疫站、環(huán)境監(jiān)測站、食品衛(wèi)生監(jiān)督檢驗所、醫(yī)院、生物制品所、藥檢所、商檢局、食品廠、飲料廠、化妝品廠、日化廠及大專院校、科研單位實驗室的必備儀器。菌落計數(shù)器包括實驗用菌落計數(shù)儀、半自動菌落計數(shù)儀、手動菌落計數(shù)儀等,下面將為您詳細介紹菌落計數(shù)器。
1.獨特倒退計數(shù)紐,解決誤點。
2.壓力敏感度和計數(shù)聲響均可調(diào)節(jié)。
3.黑白兩色底盤變化,使您針對性淺色系的樣品做調(diào)整。
4.菌落計數(shù)器主要用于對培養(yǎng)基培養(yǎng)出來的菌落群進行計數(shù)。
5.采用壓力感應式,適合各種計數(shù)筆環(huán)狀不閃爍燈管減少眼睛疲勞。

1.型號:Galaxy230
2.培養(yǎng)皿尺寸:直徑60或90~150mm
3.放大倍數(shù):2~3X
4.歸零鍵:有
5.倒退計數(shù)鍵:有
6.燈源:環(huán)狀不閃爍燈管
7.壓力敏感度:可調(diào)
8.計數(shù)聲音:可調(diào)
9.數(shù)據(jù)輸出:RS232和USB2.0
10.尺寸:313×360×346mm
11.軟件:選配
1、成像方面,傳統(tǒng)的手動菌落計數(shù)器,使用的是放大鏡,一般可放大1.7倍到3倍。現(xiàn)在使用的菌落計數(shù)器已經(jīng)具有了圖片拍攝功能,而且CCD的規(guī)格越來越高,現(xiàn)在市場上銷售的儀器所配置的CCD規(guī)格是300萬到1000萬像素不等,分辨率也從原來的0.08mm增強到了現(xiàn)在的0.01mm,圖像清晰度大大提高。另外應基層微生物實驗室的使用需求,還增加了圖像特性獲取功能。
2、圖像處理功能,具有圖像調(diào)節(jié),圖像增強,圖像濾波,邊緣檢測,形態(tài)學運算等,這些都是傳統(tǒng)的菌落計數(shù)器所沒有的。
3、在統(tǒng)計功能方面,不再局限于傳統(tǒng)的數(shù)量統(tǒng)計。現(xiàn)在市場上出現(xiàn)的全自動菌落計數(shù)器,已經(jīng)增加了一些智能識別技術(shù),可全皿菌落統(tǒng)計,區(qū)域選擇統(tǒng)計,鼠標點擊統(tǒng)計,排污區(qū)域計數(shù),直徑分類統(tǒng)計,顏色識別統(tǒng)計等。更[Cutting-edge的全自動菌落計數(shù)器還帶有自動雜質(zhì)剔除,菌落粘連分割大腸桿菌技術(shù)等等。

4、測量功能和抑菌圈自動測量方面也是原來的菌落計數(shù)器所沒有,更有[Cutting-edge的儀器已經(jīng)具有了藥敏分析功能。不過,這種菌落計數(shù)器多用在微生物實驗室等數(shù)據(jù)要求較高的領(lǐng)域,價格也不[cheapest,市場價多在8,9萬左右。
5、在數(shù)據(jù)庫的處理方面,較傳統(tǒng)的菌落計數(shù)器,增加了數(shù)據(jù)存儲,智能查詢,數(shù)據(jù)導出等,有的還可以設置操作者使用權(quán)限,數(shù)據(jù)修改權(quán)限設置等,使測量的數(shù)據(jù)更加安全。同時,還可以在線編輯,報表打印。
食品殺菌技術(shù)近幾年來逐漸被食品企業(yè)認可的一種方式。該技術(shù)在工人工作的同時,可以同步對空間空氣殺菌,對人體沒有任何傷害。使得經(jīng)高溫后基本無菌的食品半成品,流轉(zhuǎn)至冷卻、挑選、包裝及灌裝等環(huán)節(jié)時,有效降低或避免這些空氣中含有的微生物附著在食品表面,再次污染食品,有效提高車間空氣和食品衛(wèi)生質(zhì)量。極大的避免了休閑食品企業(yè)在檢測中出現(xiàn)菌落總數(shù)超標的現(xiàn)象。另外菌落計數(shù)器在這一技術(shù)中起到了非常重要的作用,菌落計數(shù)器可以把菌種放大2倍以上,以避免人為的失誤。

1.計數(shù)器測定法
即用血細胞計數(shù)器進行計數(shù)。取一定體積的樣品細胞懸液置于血細胞計數(shù)器的計數(shù)室內(nèi),用顯微鏡觀察計數(shù)。由于計數(shù)室的容積是一定的(O.1mm3),因而根據(jù)計數(shù)器刻度內(nèi)的細菌數(shù),可計算樣品中的含菌數(shù)。本法簡便易行,可立即得出結(jié)果(本法不僅適于細菌計數(shù),也適用于酵母菌及霉菌孢子計數(shù))。
2.電子計數(shù)器計數(shù)法
電子計數(shù)器的工作原理是測定小孔中液體的電阻變化,小孔僅能通過一個細胞,當一個細胞通過這個小孔時,電阻明顯增加,形成一個脈沖,自動記錄在電子記錄裝置上。
該法測定結(jié)果較[accuracy],但它只識別顆粒大小,而不能區(qū)分是否為細菌。因此,要求菌懸液中不含任何碎片。
3.活細胞計數(shù)法
常用的有平板菌落計數(shù)法,是根據(jù)每個活的細菌能長出一個菌落的原理設計的。取一定容量的菌懸液,作一系列的倍比稀釋,然后將定量的稀釋液進行平板培養(yǎng),根據(jù)培養(yǎng)出的菌落數(shù),可算出培養(yǎng)物中的活菌數(shù)。此法靈敏度高,是一種檢測污染活菌數(shù)的方法,也是目前國際上許多國家所采用的方法。使用該法應注意:①一般選取菌落數(shù)在30~300之間的平板進行計數(shù),過多或過少均不[accuracy];②為了防止菌落蔓延,影響計數(shù),可在培養(yǎng)基中加入O.001%2,3,5一氯化三苯基四氮唑(TTC);③本法限用于形成菌落的微生物。
廣泛應用于水、牛奶、食物、藥品等各種材料的細菌檢驗,是[much]常用的活菌計數(shù)法。
4.比濁法
比濁法是根據(jù)菌懸液的透光量間接地測定細菌的數(shù)量。細菌懸浮液的濃度在一定范圍內(nèi)與透光度成反比,與光密度成正比,所以,可用光電比色計測定菌液,用光密度(OD值)表示樣品菌液濃度。
此法簡便快捷,但只能檢測含有大量細菌的懸浮液,得出相對的細菌數(shù)目,對顏色太深的樣品,不能用此法測定。
5.測定細胞重量法
此法分為濕重法和干重法。濕重法系單位體積培養(yǎng)物經(jīng)離心后將濕菌體進行稱重;干重法系單位體積培養(yǎng)物經(jīng)離心后,以清水洗凈放人干燥器加熱烘干,使之失去水分然后稱重。此法適于菌體濃度較高的樣品,是測定絲狀真菌生長量的一種常用方法。
6.測定細胞總氮量或總碳量
氮、碳是細胞的主要成分,含量較穩(wěn)定,測定氮、碳的含量可以推知細胞的質(zhì)量。此法適于細胞濃度較高的樣品。
7、顏色改變單位法(colour change unit,簡稱CCU)
這種方法通常用于很小,用一般的比濁法無法計數(shù)的微生物,比如支原體等,因為支原體的液體培養(yǎng)物是完全透明的,呈現(xiàn)為清亮透明紅色,因此無法用比濁法來計數(shù),由于支原體固體培養(yǎng)很困難,用cfu法也不容易計數(shù),因此需要用特殊的計數(shù)方法,即CCU法。它是以微生物在培養(yǎng)基中的代謝活力為指標,來計數(shù)微生物的相對含量的。
1.將電源插頭插入220V電源插座內(nèi)
2.將計數(shù)筆插頭插入儀器上的插孔內(nèi)
3.將電源開關(guān)撥向“開”,計數(shù)池內(nèi)燈亮。同時數(shù)字顯示為“000”,表示允許進行計數(shù)。如數(shù)字不為“000”,應按復零鍵
4.將待檢測的培養(yǎng)皿(皿底朝上),放入計數(shù)池內(nèi)
5.用計數(shù)筆在培養(yǎng)皿底面對所有的菌落逐個點數(shù)。每點數(shù)一個應聽到“嘟”聲才說明有效,否則應重點。此時,點到的菌落被標上顏色,顯示數(shù)字自動累加。
6.用放大鏡仔細檢查,確認點數(shù)無遺漏,計數(shù)即已完畢。
7.顯示的數(shù)字即為培養(yǎng)皿內(nèi)的菌落數(shù)
8.記錄數(shù)字后取出培養(yǎng)皿,按復零鍵,顯示恢得“000”為另一培養(yǎng)皿計數(shù)做好準備。
1.菌落計數(shù)器應放置在平整牢固的試驗臺上使用。
2.點數(shù)菌落時,計數(shù)筆不要傾斜,輕輕點下至有彈跳感,聽到“嘟”聲即可,如點按過重易損壞計數(shù)筆。
3.儀器應防潮、防劇烈震動。防直接日光曝曬、防酸堿腐蝕,用后應加防塵罩。
4.注意防止細菌污染計數(shù)池。
5.如不發(fā)生計數(shù)的問題,可按動校驗鍵進行自動檢查。如計數(shù),說明計數(shù)筆壞。如仍不計數(shù)說明儀器本身有故障,請不要隨意拆卸,應請有經(jīng)驗的技術(shù)人員檢修。
1.根據(jù)實際使用需求來確定CCD傳感器的檔次
很多用戶偏向于選擇像素高的菌落計數(shù)器,卻沒考慮到檢驗和科研的實際應用需求,所以用戶在選購前就要確定好自己要買多少像素的CCD傳感器。
2.看圖像采集通道功能,指標越多越好
所謂"圖像采集通道",就是菌落計數(shù)器對于樣品信息的獲取能力,也就是標志著菌落計數(shù)器開始計數(shù)統(tǒng)計前的初始信息是否真實可靠。如果圖像采集通道功能過于單一,那當后期計數(shù)時時會很容易出現(xiàn)誤判,所以"圖像采集通道"指標越多越好。指標響應時間越小,則標志著該菌落計數(shù)器獲取樣品信息的能力越強。
3.看低至菌落分辨率為多少
一般入門級菌落計數(shù)器低至菌落分辨率多半有0.1mm左右的效果,中等機型有0.05mm的水準,若實際比較入門、高階機型的圖檔顯示能力,擁有高分辨率的計數(shù)器,在菌落較小時效果會更明顯。
4.看有沒有數(shù)據(jù)及報表管理功能
在選購菌落計數(shù)器時一定要選有具有數(shù)據(jù)及報表管理功能的設備,于由微生物的不可復檢性,對于以往檢驗數(shù)據(jù)的管理和回溯極為重要,不然在實際開展工作時繁雜的統(tǒng)計數(shù)據(jù)和報表管理會耗盡科研人員的精力。
5.不要指標高的,就要效果好的
現(xiàn)在有些菌落計數(shù)器在給用戶介紹時,會宣傳他們的產(chǎn)品有多少多少功能,多高多高的指標,實際上等真正買回家,根本用不到這么多功能,[much]重要的還是要統(tǒng)計菌落的實際效果好不好,不能為了過多的功能而買一個效果不是很好的設備。而統(tǒng)計效果的好壞關(guān)鍵在于算法是否合理。
6.看使用是否方便
全自動菌落計數(shù)器的一個主要優(yōu)點在于它降低了人工統(tǒng)計菌落的工作量,減輕了工作人員的工作強度,但由于菌落形態(tài)和樣品狀態(tài)的不確定性,市面上大多數(shù)菌落計數(shù)器都較為強調(diào)通過人工干預來提高[accuracy]度。用戶在選購設備時應注意操作是否簡便、是否符合工作人員的操作習慣和操作思路。一般來說,需要的人工干預越小,使用越簡便。
《菌落計數(shù)器各類問題匯總》由上海巴玖整理,轉(zhuǎn)截請說明。


